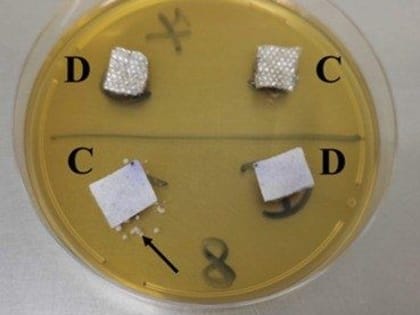

Наука и Образование

Не механический подход к подготовке механиков (видео)
Слесарь механосборочных работ. Эта специальность в Сарове становится всё более престижной.

В этом году школу с медалью в Сарове окончил 71 выпускник
5 июля в большом зале администрации города состоялось чествование саровских выпускников, награжденных медалью «За особые успехи в учении».

Вручение дипломов выпускникам
Уважаемые выпускники всех форм обучения!!!
Нижегородские ученые разработали новый способ лечения тяжелых ожогов
Ученые Приволжского исследовательского медицинского университета разработали новый способ лечения тяжелых ожогов.

В Сарове пройдут Всероссийские соревнования по авиамодельному спорту
15 и 16 июля – в классе кордовых пилотажных моделей самолетов;

Фестиваль «Вектор успеха» ждет участников
Открыта регистрация на участие во Всероссийском фестивале популяризации науки «Вектор успеха».

Первые специалисты фундаментальной медицины выпустились из ННГУ 7 июля
Первый выпуск врачей фундаментальной медицины прошел в Нижнем Новгороде 7 июля.

Михаил Мишустин поручил проработать развитие учебного кластер МГУ в Сарове
Премьер-министр РФ Михаил Мишустин по итогам рабочей поездки в Саров поручил проработать развитие учебного кластер МГУ в городе атомщиков.

Мишустин распорядился о развитии учебного кластера МГУ в Сарове
Михаил Мишустин поручил проработать развитие учебного кластера МГУ в Сарове Нижегородской области.

Вручение дипломов бакалавров выпускникам СарФТИ НИЯУ МИФИ состоится 11 июля
Уважаемые выпускники бакалавриата, преподаватели и сотрудники СарФТИ НИЯУ МИФИ!